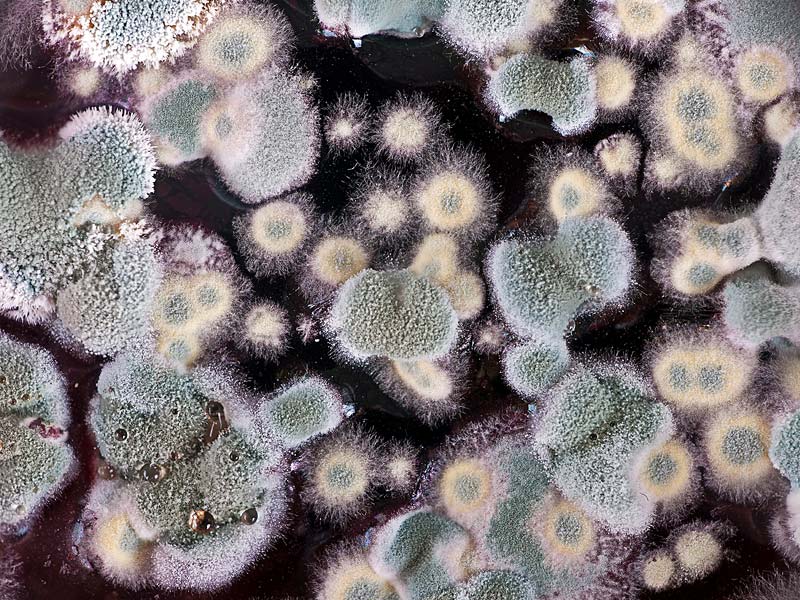
2e4afa3a-2605-4a4d-9c48-016e9d14d5eb

Fungus Allergy
Aspergillus is fungus specie that reproduces in hot and damp environments. They can exist in houses or atmosphere. Every aspergillus has a season that reproduces faster, but aspergillus generally reproduce in summer and autumn. Although aspergillus exists in air year through, the amount in atmosphere rapidly reduces in winter. When snow covers earth, aspergillus does not exist in air.
There are thousands of kinds of aspergillus, but some of them cause allergy. Little particles of aspergillus called spore is responsible for allergic illnesses. Aspergillus on food for instance on cheese rarely cause allergic reactions. Aspergillus kind of an environment depends on climate, vegetation, centre of population (village, town, city). Recent changes in our life style has increased the damp proportion in houses. That means aspergillus amount has been increased as well.
Aspergillus frequently exists in humidity and dark places such as kitchen, pantry, bathroom, toilet etc. Rotten floors, carpets, quilts and cushions, bathroom walls, foam sponges, window edges are places where aspergillus most like. Although they can exist in the air of house whole year, their amount is much more in summer and autumn.
Some kind of aspergillus like dry and windy weather, some like damp and rainy weather. During the operations related to agriculture such as gross cutting, raking etc., plenty of fungus spores exist in air. Serious discomforts emerge on sensitive people during these operations. Aspergillus might cause many illnesses such as allergic eye illness, straw catarrh, skin allergies, asthma and allergic pneumonia.
PRECAUTIONS TO BE TAKEN IN HOUSE
Spaces where aspergillus reproduces should be taken away. Since fungus is one of the food sources of mites, if aspergillus amount is reduced it will be useful on account of mite allergies. If there is mould on bathroom curtains they must be washed in the machine with hot water with detergent and chlorinated water. Wet carpets and woven matting are ideal spaces for aspergillus to reproduce; these should be removed from house. Since flower-pots in houses are suitable reproducing places for aspergillus, they shouldn’t be kept in bedrooms. Since everybody sweats more or less while sleeping, cushions get wet and aspergillus might reproduce especially on foam-rubber cushions. Therefore to cover cushions and quilts with a special covering will be useful. Washing damp walls with diluted chlorinated water or muriatic acid stops aspergillus to reproduce. Bath tanks, sinks, douches and toilets should never be left dirty and wet. The indoor air should be cleaned with Roboclean.